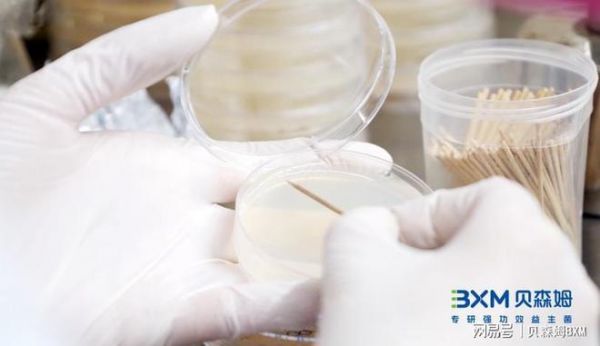

脑肠轴与心理健康:益生菌的新视角
在现代医学研究中,脑肠轴(gut-brain axis)这一概念逐渐受到关注。脑肠轴是指肠道与大脑之间通过神经、内分泌、免疫等多种途径进行双向交流和调节的复杂网络。近年来,越来越多的研究表明,脑肠轴在心理健康和多种神经精神疾病中扮演着重要角色。而益生菌作为调节肠道微生物群的重要手段,正在成为心理健康领域的新兴研究热点。

脑肠轴:从肠道到大脑的双向交流
脑肠轴的核心是肠道微生物群与中枢神经系统的相互作用。肠道内的微生物通过产生短链脂肪酸(如丁酸盐)、神经递质(如5-羟色胺)以及免疫调节因子,直接或间接地影响大脑功能。反过来,大脑也通过自主神经系统和下丘脑-垂体-肾上腺轴(HPA轴)调控肠道功能。
2022年2月14日,发表在顶尖学术期刊《自然》(Nature)上的一项新研究中,来自美国加州理工学院陈天桥雒芊芊脑科学研究院微生物学教授Sarkis Mazmanian领导的研究团队,发现了肠道和大脑之间传递的分子信息:一种肠道细菌产生的小分子代谢物可以进入小鼠大脑并改变脑细胞功能,从而导致动物的焦虑行为加剧。该研究为肠道菌群变化与复杂情绪行为之间的联系提供了分子水平的证据。

研究发现,肠道菌群的失衡(如菌群多样性减少或有害菌增多)可能与焦虑、抑郁、自闭症等多种精神疾病相关。例如,患有抑郁症的患者常常伴有肠道菌群的显著变化,提示肠道微生物可能在这些疾病的发生和发展中起到一定作用。
益生菌:调节肠道菌群的新希望
益生菌是指对宿主有益的活性微生物,主要通过调节肠道菌群、增强肠道屏障功能、调节免疫反应等途径发挥作用。近年来,越来越多的研究表明,特定的益生菌菌株在改善心理健康方面具有潜力。
益生菌对焦虑和抑郁的影响
多项动物实验和临床研究表明,某些益生菌菌株(如乳酸菌和双歧杆菌)能够减轻焦虑和抑郁症状[1]。例如,一项研究发现,服用乳酸菌的实验小鼠表现出较低的焦虑行为和较高的5-羟色胺水平[2]。另一项临床试验则显示,服用双歧杆菌的抑郁症患者其症状显著改善[3]。一项发表于《胃肠病学》(Gastroenterology)的研究发现,患有肠易激综合征(IBS)的患者在服用特定益生菌后,焦虑和抑郁症状显著减轻。另一项研究则表明,服用益生菌饮品的健康志愿者在应对压力时表现出更好的情绪稳定性和较低的皮质醇水平[4]。

▲从前VS现在对抑郁焦虑症的理解
益生菌对认知功能的影响
益生菌还被发现对认知功能具有潜在的积极影响。一项研究表明,服用特定益生菌的老年人在记忆测试中的表现优于对照组[5]。此外,益生菌还可能通过减少炎症和氧化应激,保护神经元,进而改善认知功能。在阿尔茨海默病等认知障碍的研究中,益生菌也表现出潜在的治疗作用。某些益生菌菌株能够减少阿尔茨海默病模型小鼠的大脑中β-淀粉样蛋白的积聚,改善其认知功能[6]。这为益生菌在认知障碍治疗中的应用提供了新的可能。
贝森姆的强功效益生菌:为心理健康护航
贝森姆(BIOXMAS)是一家具有国际化产学研背景的益生菌科技企业,长期专注强功效益生菌的研发、生产与产品化应用,掌握强功效益生菌核心研发能力及生产技术,拥有多株明星专利菌株,能够为客户提供以强功效为导向、满足消费者多元需求的精准、科学、有效的益生菌产品解决方案。贝森姆致力于通过科学的方法筛选和优化益生菌菌株,以期在心理健康领域取得突破。贝森姆的研究团队采用先进的组学技术和临床试验,验证了多种益生菌在调节情绪、改善认知功能方面的效果。
▲贝森姆研发人员进行菌种筛选的画面
脑肠轴与心理健康的关系为我们提供了一个全新的视角,益生菌作为调节肠道微生物群的重要手段,正在成为改善心理健康的新希望。贝森姆致力于通过科学研究和创新,推出强功效益生菌产品,为广大消费者的心理健康保驾护航。在未来,益生菌或将成为心理健康领域的重要一环,帮助更多人实现身心的和谐与健康。
参考来源:
[1] Mohammadi, Ali & Jazayeri, Shima & Khosravi, Kianoush & Solati, Zahra & Mohammadpour, Nakisa & Asemi, Zatollah & Adab, Zohre & Djalali, Mahmoud & Tehrani-Doost, Mehdi & Hosseini, Mostafa & Eghtesadi, Shahryar. (2015). The effects of probiotics on mental health and hypothalamic–pituitary–adrenal axis: A randomized, double-blind, placebo-controlled trial in petrochemical workers. Nutritional neuroscience. 19. 10.1179/1476830515Y.0000000023.
[2] Messaoudi, Michaël & Lalonde, Robert & Violle, Nicolas & Javelot, Hervé & Desor, Didier & Nejdi, Amine & Bisson, Jean-François & Rougeot, Catherine & Pichelin, Matthieu & Cazaubiel, Murielle & Cazaubiel, Jean-Marc. (2010). Assessment of psychotropic-like properties of a probiotic fomulation (Lactobacillus helveticus R0052 and Bifidobacterium longum R0175) in rats and human subjects. The British journal of nutrition. 105. 755-64. 10.1017/S0007114510004319.
[3] Kazemi, Asma & Noorbala, Ahmad & Azam, Kamal & Eskandari, Mohammad Hadi & Djafarian, Kurosh. (2018). Effect of probiotic and prebiotic vs placebo on psychological outcomes in patients with major depressive disorder: A randomized clinical trial. Clinical Nutrition. 38. 10.1016/j.clnu.2018.04.010.
[4] Talbott, Shawn & Talbott, Julie & Stephens, Bret & Oddou, Marc. (2019). Effect of Coordinated Probiotic/Prebiotic/Phytobiotic Supplementation on Microbiome Balance and Psychological Mood State in Healthy Stressed Adults. Functional Foods in Health and Disease. 9. 265-275. 10.31989/ffhd.v9i4.599.
[5] Messaoudi, Michaël & Lalonde, Robert & Violle, Nicolas & Javelot, Hervé & Desor, Didier & Nejdi, Amine & Bisson, Jean-François & Rougeot, Catherine & Pichelin, Matthieu & Cazaubiel, Murielle & Cazaubiel, Jean-Marc. (2010). Assessment of psychotropic-like properties of a probiotic fomulation (Lactobacillus helveticus R0052 and Bifidobacterium longum R0175) in rats and human subjects. The British journal of nutrition. 105. 755-64. 10.1017/S0007114510004319.
[6] Observational study finds link between use of biotics and cognitive health
[7] 02-Aug-2023 By Nikki Hancocks
特别声明:以上内容(如有图片或视频亦包括在内)为自媒体平台“网易号”用户上传并发布,本平台仅提供信息存储服务。
Notice: The content above (including the pictures and videos if any) is uploaded and posted by a user of NetEase Hao, which is a social media platform and only provides information storage services.
相关知识
微生物与抑郁症:肠道与心理健康的新视角
肠道微生物组与心理健康的隐秘对话:脑肠轴机制与干预新视角——基于微生物组调控的情绪与认知科学进展
靶向脑肠轴:针灸调节抑郁失眠的新视角
解锁肠脑轴密码,cns藏红花益生菌成养护肠道的全新策略
益生菌能否改善你的心理健康?了解肠
肠脑轴:改善健康的 5 个突破性见解
肠脑轴线:连接您的大脑和微生物群
脑肠轴再添力证,调节肠道菌群或为改善认知障碍疾病带来裨益
脑肠轴——肠道影响精神健康
重塑肠道微生态:益生菌与健康的奥秘
网址: 脑肠轴与心理健康:益生菌的新视角 https://www.trfsz.com/newsview1880005.html
推荐资讯
- 1发朋友圈对老公彻底失望的心情 12775
- 2BMI体重指数计算公式是什么 11235
- 3补肾吃什么 补肾最佳食物推荐 11199
- 4性生活姿势有哪些 盘点夫妻性 10428
- 5BMI正常值范围一般是多少? 10137
- 6在线基础代谢率(BMR)计算 9652
- 7一边做饭一边躁狂怎么办 9138
- 8从出汗看健康 出汗透露你的健 9063
- 9早上怎么喝水最健康? 8613
- 10五大原因危害女性健康 如何保 7828






